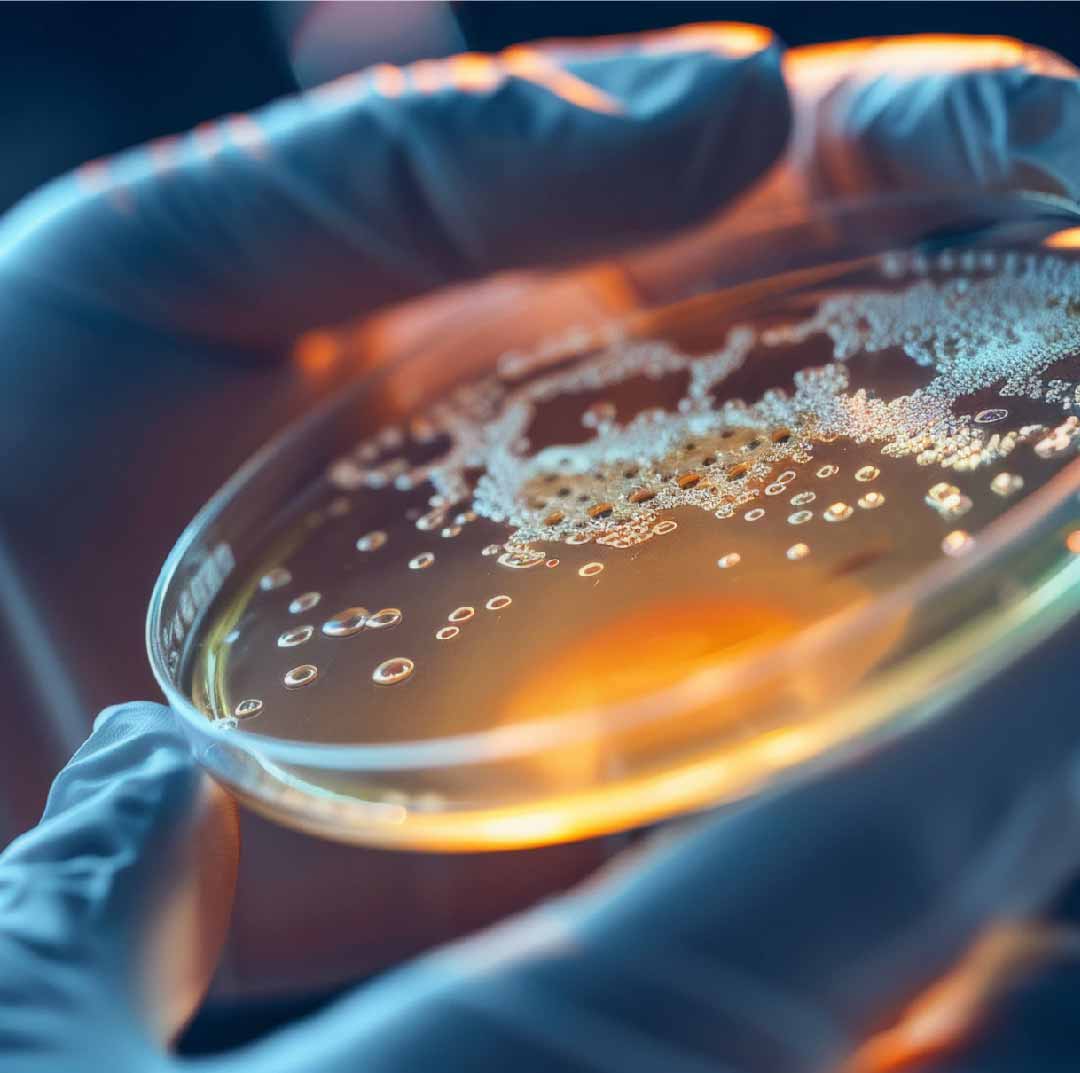

Kontakt
info@tovasan.de
Wiesenweg 22
D - 69151 Neckargemünd
Kontaktformular

Zulassungen
Technische Parameter
Hier erhältst du einen Überblick über unsere Zulassungen. Bitte frage nach, wenn Du mehr wissen möchtest.

Alkoholbasierte Handdesinfektion
Alkohol dringt über die Haut ins Blut
Wissenschaftlich nachgewiesen: Alkoholbasierte Desinfektionsmittel dringen über die Haut ins Blut. Gemessen kann dieser Effekt sogar in vergleichbaren Biermengen.
Desinfektion im Labor
Was ist eigentlich... Desinfektion?
Hast du schon mal im Handel Desinfektion mit einem Wirkgrad von 99,99 oder 99,9 gesehen? Das ist keine Desinfektion... unglaublich dreist, was im Handel so unter Desinfektion läuft. Und dabei unsere Gesundheit gefährdet.